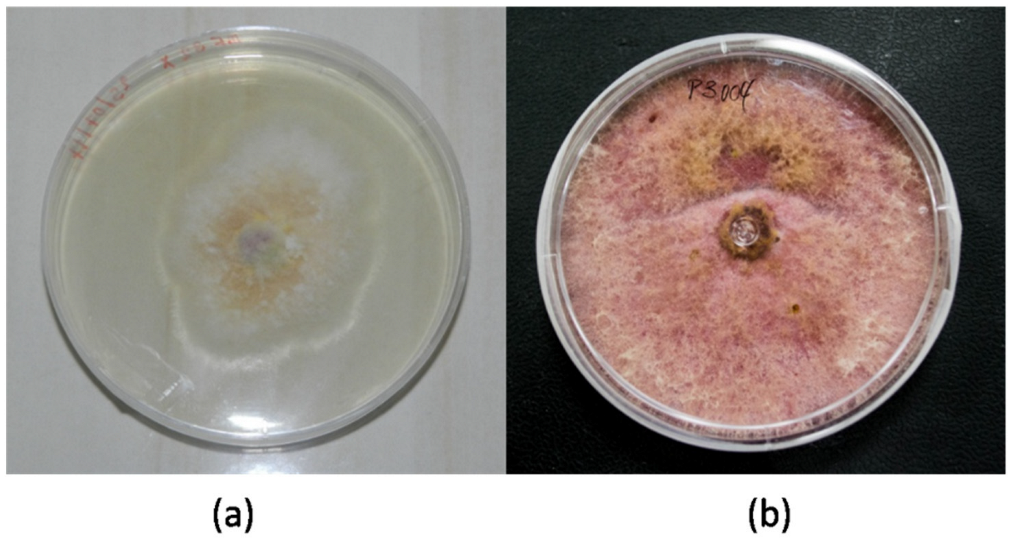
Jof 08 00399 g003

Thermo-Mechanical and Fungi Treatment as an Alternative Lignin Degradation Method for Bambusa oldhamii and Guadua angustifolia Fibers
Abstract
:1. Introduction
- (1)
- Collect the sample (natural fibers and agro industrial waste), in this particular case, B. oldhamii Munro the Giant Bamboo (GB) and G. angustifolia Kunt (GAK);
- (2)
- The thermo-mechanical process, i.e., using steam pressure and mechanical sieving to obtain microfibers of different lengths according to American Society for Testing and Materials, ASTM standard E11 (2017);
- (3)
- The fungal treatment, i.e., the microfibers of GB and GAK were then treated with F. incarnatum-equiseti MF18MH45591 strain in a 21 d degradation process;
- (4)
- The untreated control and treated samples were analyzed via optical microscopy and Fourier transform infrared (FTIR) spectroscopy; and
- (5)
- A multivariate analysis of the principal components was employed to confirm possible changes in the spectral region of interest (ROI).
2. Materials and Methods
2.1. Materials
2.2. Fungal Isolation and Morpho-Molecular Characterization
2.3. Fungal Delignification of the Vegetable Fibers
2.4. Attenuated Total Reflection Fourier Transform Infrared (ATR-FTIR) Spectra
2.5. Principal Component Analysis
3. Results
3.1. Morphological Characteristics
3.2. Phylogenetic Analysis
3.3. Fungal Delignification of the Vegetal Fibers
3.4. Attenuated Total Reflection Fourier Transform Infrared (ATR-FTIR)
3.5. Principal Component Analysis
4. Discussion
5. Conclusions
Author Contributions
Funding
Institutional Review Board Statement
Informed Consent Statement
Data Availability Statement
Conflicts of Interest
References
- Zou, L.; Jin, H.; Lu, W.-Y.; Li, X. Nanoscale structural and mechanical characterization of the cell wall of bamboo fibers. Mater. Sci. Eng. C 2009, 29, 1375–1379. [Google Scholar] [CrossRef]
- Wahab, R.; Tamizi, M. Extractives, Holocellulose, & alphaCellulose, Lignin and Ash Contents in Cultivated Tropical Bamboo Gigantochloa brang, G. levis, G. scortechinii and G. wrayi. Curr. Res. J. Biol. Sci. 2013, 5, 266–272. [Google Scholar]
- Xu, G.; Wang, L.; Liu, J.; Wu, J. FTIR and XPS analysis of the changes in bamboo chemical structure decayed by white-rot and brown-rot fungi. Appl. Surf. Sci. 2013, 280, 799–805. [Google Scholar] [CrossRef]
- Liu, H.; He, P.; He, L.; Li, Q.; Cheng, J.; Wang, Y.; Yang, G.; Yang, B. Structure characterization and hypoglycemic activity of an arabinogalactan from Phyllostachys heterocycla bamboo shoot shell. Carbohydr. Polym. 2018, 201, 189–200. [Google Scholar] [CrossRef]
- Trujillo, E.; Trujillo, E.; Montoya, L. Estudio de las características físicas de haces de fibra de Guadua Angustifolia. Sci. Tech. 2007, 1, 34. [Google Scholar]
- Okubo, K.; Fujii, T.; Yamamoto, Y. Development of bamboo-based polymer composites and their mechanical properties. Compos. Part A Appl. Sci. Manuf. 2004, 35, 377–383. [Google Scholar] [CrossRef]
- Zuluaga, R.; Putaux, J.L.; Cruz, J.; Vélez, J.; Mondragon, I.; Gañan, P. Cellulose microfibrils from banana rachis: Effect of alkaline treatments on structural and morphological features. Carbohydr. Polym. 2009, 76, 51–59. [Google Scholar] [CrossRef]
- Delgado, P.S.; Lana, S.L.B.; Ayres, E.; Patricio, P.O.S.; Oréfice, R.L. The potential of bamboo in the design of polymer composites. Mater. Res. 2012, 15, 639–644. [Google Scholar] [CrossRef] [Green Version]
- Alves Fidelis, M.E.; Pereira, T.V.C.; Gomes, O.v.d.F.M.; de Andrade Silva, F.v.; Toledo Filho, R.D. The effect of fiber morphology on the tensile strength of natural fibers. J. Mater. Res. Technol. 2013, 2, 149–157. [Google Scholar] [CrossRef] [Green Version]
- del Río, J.C.; Gutiérrez, A.; Martínez, Á.T. Identifying acetylated lignin units in non-wood fibers using pyrolysis-gas chromatography/mass spectrometry. Rapid Commun. Mass Spectrom. 2004, 18, 1181–1185. [Google Scholar] [CrossRef] [Green Version]
- Feldman, D. Wood—Chemistry, ultrastructure, reactions, by D. Fengel and G. Wegener, Walter de Gruyter, Berlin and New York, 1984, 613. J. Polym. Sci. Polym. Lett. Edit. 1985, 23, 601–602. [Google Scholar] [CrossRef]
- Abdul Khalil, H.P.S.; Bhat, I.U.H.; Jawaid, M.; Zaidon, A.; Hermawan, D.; Hadi, Y.S. Bamboo fibre reinforced biocomposites: A review. Mater. Des. 2012, 42, 353–368. [Google Scholar] [CrossRef]
- Duan, Y.; Awasthi, S.K.; Chen, H.; Liu, T.; Zhang, Z.; Zhang, L.; Awasthi, M.K.; Taherzadeh, M.J. Evaluating the impact of bamboo biochar on the fungal community succession during chicken manure composting. Bioresour. Technol. 2019, 272, 308–314. [Google Scholar] [CrossRef] [PubMed]
- Cui, C.; Sadeghifar, H.; Sen, S.; Argyropoulos, D.S. Toward Thermoplastic Lignin Polymers; Part II: Thermal & Polymer Characteristics of Kraft Lignin & Derivatives. BioResources 2013, 8, 864–886. [Google Scholar]
- Li, H.; Deng, Y.; Liang, J.; Dai, Y.; Li, B.; Ren, Y.; Qiu, X.; Li, C. Direct Preparation of Hollow Nanospheres with Kraft Lignin: A Facile Strategy for Effective Utilization of Biomass Waste. BioResources 2016, 11, 3073–3083. [Google Scholar] [CrossRef] [Green Version]
- Kaushik, A.; Singh, M. Isolation and characterization of cellulose nanofibrils from wheat straw using steam explosion coupled with high shear homogenization. Carbohydr. Res. 2011, 346, 76–85. [Google Scholar] [CrossRef]
- Wen, J.-L.; Xiao, L.-P.; Sun, Y.-C.; Sun, S.-N.; Xu, F.; Sun, R.-C.; Zhang, X.-L. Comparative study of alkali-soluble hemicelluloses isolated from bamboo (Bambusa rigida). Carbohydr. Res. 2011, 346, 111–120. [Google Scholar] [CrossRef]
- George, G.; Tomlal Jose, E.; Jayanarayanan, K.; Nagarajan, E.R.; Skrifvars, M.; Joseph, K. Novel bio-commingled composites based on jute/polypropylene yarns: Effect of chemical treatments on the mechanical properties. Compos. Part A Appl. Sci. Manuf. 2012, 43, 219–230. [Google Scholar] [CrossRef]
- Isroi, I.; Millati, R.; Syamsiah, S.; Niklasson, C.; Cahyanto, M.N.; Ludquist, K.; Taherzadeh, M.J. Biological Pretreatment of lignocelluloses with white-rot fungi and its applications: A review. BioResources 2011, 6, 5224–5259. [Google Scholar] [CrossRef]
- Madadi, M.; Abbas, A. Lignin Degradation by Fungal Pretreatment: A Review. J. Plant Pathol. Microbiol. 2017, 8, 398. [Google Scholar]
- Mwaikambo, L.Y.; Ansell, M.P. Chemical modification of hemp, sisal, jute, and kapok fibers by alkalization. J. Appl. Polym. Sci. 2002, 84, 2222–2234. [Google Scholar] [CrossRef]
- Wang, H.; Huang, L.; Lu, Y. Preparation and characterization of micro- and nano-fibrils from jute. Fibers Polym. 2009, 10, 442–445. [Google Scholar] [CrossRef]
- He, L.; Li, X.; Li, W.; Yuan, J.; Zhou, H. A method for determining reactive hydroxyl groups in natural fibers: Application to ramie fiber and its modification. Carbohydr. Res. 2012, 348, 95–98. [Google Scholar] [CrossRef] [PubMed]
- Afrin, T.; Tsuzuki, T.; Wang, X. UV absorption property of bamboo. J. Text. Inst. 2012, 103, 394–399. [Google Scholar] [CrossRef] [Green Version]
- Brígida, A.I.S.; Calado, V.M.A.; Goncalves, L.R.B.; Coelho, M.A.Z. Effect of chemical treatments on properties of green coconut fiber. Carbohydr. Polym. 2010, 79, 832–838. [Google Scholar] [CrossRef]
- Fiore, V.; Scalici, T.; Valenza, A. Characterization of a new natural fiber from Arundo donax L. as potential reinforcement of polymer composites. Carbohydr. Polym. 2014, 106, 77–83. [Google Scholar] [CrossRef]
- Chen, H.-Z.; Liu, Z.-H. Steam explosion and its combinatorial pretreatment refining technology of plant biomass to bio-based products. Biotech. J. 2015, 10, 866–885. [Google Scholar] [CrossRef]
- ASTME11. Standard Specification for Woven Wire Test Sieve Cloth and Test Sieves; ASTM International: West Conshohocken, PA, USA, 2017. [Google Scholar]
- Seifert, K.A.; Gams, W. The genera of Hyphomycetes-2011 update. Persoonia 2011, 27, 119–129. [Google Scholar] [CrossRef] [Green Version]
- White, T.J.; Bruns, T.; Lee, S.; Taylor, J. 38-Amplification and direct sequencing of fungal ribosomal RNA genes for phylogenetics. In PCR Protocols; Innis, M.A., Gelfand, D.H., Sninsky, J.J., White, T.J., Eds.; Academic Press: San Diego, CA, USA, 1990; pp. 315–322. [Google Scholar]
- Cruz, D.; Suárez, J.P.; Kottke, I.; Piepenbring, M. Cryptic species revealed by molecular phylogenetic analysis of sequences obtained from basidiomata of Tulasnella. Mycologia 2014, 106, 708–722. [Google Scholar] [CrossRef]
- Polly, P.D.; Lawing, A.M.; Fabre, A.-C.; Goswami, A. Phylogenetic Principal Components Analysis and Geometric Morphometrics. Hystrix Ital. J. Mamm. 2013, 24, 33–41. [Google Scholar]
- Matwijczuk, A.; Oniszczuk, T.; Matwijczuk, A.; Chruściel, E.; Kocira, A.; Niemczynowicz, A.; Wójtowicz, A.; Combrzyński, M.; Wiącek, D. Use of FTIR Spectroscopy and Chemometrics with Respect to Storage Conditions of Moldavian Dragonhead Oil. Sustainability 2019, 11, 6414. [Google Scholar] [CrossRef] [Green Version]
- Dashtban, M.; Schraft, H.; Qin, W. Fungal Bioconversion of Lignocellulosic Residues; Opportunities; and Perspectives. Int. J. Biol. Sci. 2009, 5, 578–595. [Google Scholar] [CrossRef] [PubMed]
- Paudel, Y.; Qin, W. Two Bacillus Species Isolated from Rotting Wood Samples are Good Candidates for the Production of Bioethanol using Agave Biomass. J. Microb. Biochem. Technol. 2015, 7, 218–225. [Google Scholar]
- Sánchez, C. Lignocellulosic residues: Biodegradation and bioconversion by fungi. Biotech. Adv. 2009, 27, 185–194. [Google Scholar] [CrossRef]
- Ljungdahl, L.G. The Cellulase/Hemicellulase System of the Anaerobic FungusOrpinomycesPC-2 and Aspects of Its Applied Use. Ann. N. Y. Acad. Sci. 2008, 1125, 308–321. [Google Scholar] [CrossRef] [PubMed]
- Sigoillot, J.-C.; Berrin, J.-G.; Bey, M.; Lesage-Meessen, L.; Levasseur, A.; Lomascolo, A.; Record, E.; Uzan-Boukhris, E. Fungal Strategies for Lignin Degradation. Adv. Bot. Res. 2012, 61, 263–308. [Google Scholar]

| Natural Fiber | Wave Number (cm−1) | Description | References |
|---|---|---|---|
| Jute/Ramie | 3400 | OH stretching | [21,22,23] |
| 2900 | CH stretching | ||
| 1040 to 1060 | CO stretching vibration cellulose | ||
| 1550–1650 | Aromatic skeleton lignin | ||
| Bamboo | 3800 to 3300 | OH stretching vibration | [24] |
| 2921.63 | CH stretching cell/hemicellulose | ||
| 2853.17 | OH stretching vibration of inter and intramolecular H-bonding | ||
| 1733.69 | CO stretching of carboxylic acid or ester | ||
| 1636.3 | Absorbed water | ||
| 1608.34 | C=C stretching vibration of lignin | ||
| 1464 to 1530 | Lignin components | ||
| 1436.7 | >CH2 bending in lignin | ||
| 1419.3 | >CH2 and =CH3 bending | ||
| 1384.6 | CH bending | ||
| 1363 | >CO stretching of acetyl ring | ||
| 1339 | >CO stretching of acetyl ring | ||
| 1160.9 | Antisymmetric bridge C=0=C stretching | ||
| Coconut | 3340 | OH hydrogen bonded | [25] |
| 1728 | Bands of hemicellulose | ||
| 1390 | Antisymmetrical deformation of CH in cellulose and hemicellulose group | ||
| 1370 | Symmetrical deformation of CH in cellulose and hemicellulose group | ||
| 1238 | CO vibration of esters, ethers, and phenols | ||
| Arundo Donax | 3400 | OH stretching vibration hydrogen bond of hydroxyl group | [26] |
| 2923 | CH stretching vibration from CH and CH2 in cellulose and hemicellulose | ||
| 1730 | C=O stretching vibration of the acetyl group in hemicellulose | ||
| 1594 | Water in fibers | ||
| 1506 | C=C stretching of benzene ring in lignin | ||
| 1422 | CH2 symmetric bending |
Publisher’s Note: MDPI stays neutral with regard to jurisdictional claims in published maps and institutional affiliations. |
© 2022 by the authors. Licensee MDPI, Basel, Switzerland. This article is an open access article distributed under the terms and conditions of the Creative Commons Attribution (CC BY) license (https://creativecommons.org/licenses/by/4.0/).
Share and Cite
Garzón, L.; Fajardo, J.I.; Rodriguez-Maecker, R.; Fernández, E.D.; Cruz, D. Thermo-Mechanical and Fungi Treatment as an Alternative Lignin Degradation Method for Bambusa oldhamii and Guadua angustifolia Fibers. J. Fungi 2022, 8, 399. https://doi.org/10.3390/jof8040399
Garzón L, Fajardo JI, Rodriguez-Maecker R, Fernández ED, Cruz D. Thermo-Mechanical and Fungi Treatment as an Alternative Lignin Degradation Method for Bambusa oldhamii and Guadua angustifolia Fibers. Journal of Fungi. 2022; 8(4):399. https://doi.org/10.3390/jof8040399
Chicago/Turabian StyleGarzón, Luis, Jorge I. Fajardo, Román Rodriguez-Maecker, Ernesto Delgado Fernández, and Darío Cruz. 2022. "Thermo-Mechanical and Fungi Treatment as an Alternative Lignin Degradation Method for Bambusa oldhamii and Guadua angustifolia Fibers" Journal of Fungi 8, no. 4: 399. https://doi.org/10.3390/jof8040399
APA StyleGarzón, L., Fajardo, J. I., Rodriguez-Maecker, R., Fernández, E. D., & Cruz, D. (2022). Thermo-Mechanical and Fungi Treatment as an Alternative Lignin Degradation Method for Bambusa oldhamii and Guadua angustifolia Fibers. Journal of Fungi, 8(4), 399. https://doi.org/10.3390/jof8040399

